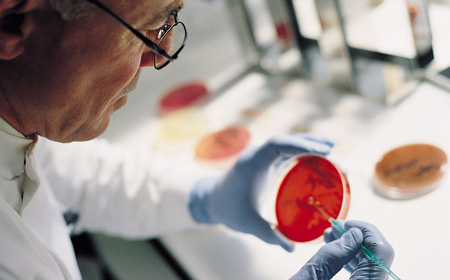

Testaments-Spende
Hilfe über das eigene Leben hinaus
Alles hat seine Zeit – heißt es in der Heiligen Schrift. Wenn man ein großes Stück Lebensweg gegangen und möglicherweise ohne Nachkommen oder alleinstehend ist, dann denkt man schon öfter einmal daran, was aus dem Angesparten und Erarbeiteten wird, wenn man einmal nicht mehr ist. Vielleicht ist für die weitere Familie, für die Neffen und Nichten, für liebe Freunde ausreichend gesorgt, und man macht sich Gedanken darüber, was aus der Wohnung, dem Haus oder dem angesparten Geldvermögen später wird.
Was auch immer die Beweggründe sind, dass man sich Gedanken über den eigenen Nachlass macht, man möchte, dass das in vielen Jahren und Jahrzehnten hart Erarbeitete und durch sparsame Lebensführung Gesicherte, in gute Hände kommt. Man möchte mit dem, was man für das eigene Leben nicht mehr braucht, Sinnvolles und Gutes bewirken.
Menschen, die uns mit einer Erbschaft oder einem Vermächtnis unterstützen, sind wir zu größtem Dank verpflichtet. Sie beweisen durch ihre großherzige Entscheidung Solidarität und Hilfsbereitschaft noch über das eigene Leben hinaus. Sie schenken den vielen auf Besserung hoffenden arthrosekranken Menschen Mut und Zuversicht.
Nachfolgend findet sich unter "Testament" ein Kurzüberblick über wichtige Informationen zur Errichtung eines Testaments. Unter "Mein Testament – Geschenk an das Leben" kann man den umfangreichen, 48-seitigen Testamentsratgeber mit vielen wertvollen Hinweisen und Empfehlungen zu diesem persönlichen Thema kostenlos bestellen.
Wählen Sie gern:
Informationsheft: Mein Testament – Geschenk an das Leben